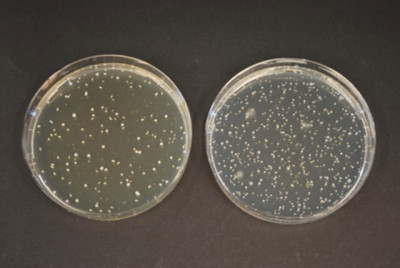
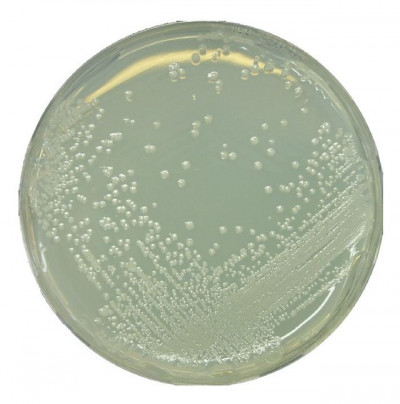

آزمیران
دستگاهای آزمایشگاهی
مواد شیمیایی
شیشه آلات
محیط کشتهای میکروبی
فیلتر یا کاغذ صافی
ملزومات
سکوبندی
مقالات و توضیحات
جستجوهای مرتبط